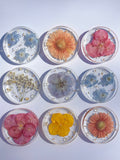
Custom Resin Coaster

Size: 10cm diameter, 1.5-2cm thick
What’s the difference between the Resin Coaster and the Resin Round Tray?
The Resin Round Tray has a raised lip around the edge and can be used as a coaster, however it is thinner in depth. This means it’s best suited to flatter flowers and petals.
The Custom Resin Coaster is thicker, allowing more depth, which makes it perfect for preserving small whole flowers and more dimensional blooms.
Preservation Piece: This product is specifically designed for preservation of your items. You need to supply the items you'd like inside. For standard resin tray products, visit this page. Please note, custom preservation pieces usually take 4-8 weeks depending on the drying process and products purchased.
IMPORTANT: After ordering this product, you'll receive an email with shipping instructions and an information form. Please print out this form, fill it out, and post to us with your flowers. Any questions, at all, please contact us.
How it works: